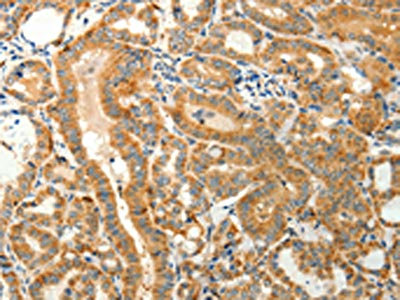

TMSB4X Antibody
-
中文名稱:TMSB4X兔多克隆抗體
-
貨號:CSB-PA952464
-
規(guī)格:¥1100
-
圖片:
-
The image on the left is immunohistochemistry of paraffin-embedded Human liver cancer tissue using CSB-PA952464(TMSB4X Antibody) at dilution 1/30, on the right is treated with synthetic peptide. (Original magnification: ×200)
-
The image on the left is immunohistochemistry of paraffin-embedded Human thyroid cancer tissue using CSB-PA952464(TMSB4X Antibody) at dilution 1/30, on the right is treated with synthetic peptide. (Original magnification: ×200)
-
-
其他:
產(chǎn)品詳情
-
Uniprot No.:
-
基因名:
-
別名:Fx antibody; Hematopoietic system regulatory peptide antibody; Prothymosin beta 4 antibody; PTMB 4 antibody; PTMB4 antibody; Seraspenide antibody; T beta 4 antibody; T beta-4 antibody; TB4X antibody; THYB 4 antibody; Thyb4 antibody; Thymosin beta 4 antibody; Thymosin beta 4 X chromosome antibody; Thymosin beta 4 X linked antibody; TMSB 4 antibody; TMSB4 antibody; Tmsb4x antibody; TYB4_HUMAN antibody
-
宿主:Rabbit
-
反應(yīng)種屬:Human,Mouse,Rat
-
免疫原:Synthetic peptide of Human TMSB4X
-
免疫原種屬:Homo sapiens (Human)
-
標(biāo)記方式:Non-conjugated
-
抗體亞型:IgG
-
純化方式:Antigen affinity purification
-
濃度:It differs from different batches. Please contact us to confirm it.
-
保存緩沖液:-20°C, pH7.4 PBS, 0.05% NaN3, 40% Glycerol
-
產(chǎn)品提供形式:Liquid
-
應(yīng)用范圍:ELISA,IHC
-
推薦稀釋比:
Application Recommended Dilution ELISA 1:2000-1:5000 IHC 1:25-1:100 -
Protocols:
-
儲存條件:Upon receipt, store at -20°C or -80°C. Avoid repeated freeze.
-
貨期:Basically, we can dispatch the products out in 1-3 working days after receiving your orders. Delivery time maybe differs from different purchasing way or location, please kindly consult your local distributors for specific delivery time.
-
用途:For Research Use Only. Not for use in diagnostic or therapeutic procedures.
相關(guān)產(chǎn)品
靶點詳情
-
功能:Plays an important role in the organization of the cytoskeleton. Binds to and sequesters actin monomers (G actin) and therefore inhibits actin polymerization.; Seraspenide inhibits the entry of hematopoietic pluripotent stem cells into the S-phase.
-
基因功能參考文獻:
- Serum Tbeta4 level can be used as a biomarker for the diagnosis of NASH and was negatively correlated with the oxidation state of the liver PMID: 29271227
- we suggest that overexpression of Tbeta4 might play a role in the progression of gastric gastrointestinal stromal tumors PMID: 28756979
- Tbeta4 exerts a protective effect on murine colitis, indicating that recombinant adeno-associated virus carrying thymosin beta4 could potentially be developed into a promising agent for the therapy of inflammatory bowel diseases. PMID: 28127198
- Results showed that the TMSB4 pseudogene, lncRNA-MSR, was upregulated in the damaged cartilage and was activated in chondrocytes in response to mechanical stress. Furthermore, lncRNA-MSR regulated the expression of TMSB4 by competing with miRNA-152 in chondrocytes. PMID: 27469625
- Tbeta4 gene silencing in A549 and H1299 cells inhibited cell proliferation, migration, and invasion in vitro and decreased tumor growth in vivo. Mechanistic investigations revealed a significant decrease in Notch1 activation in Tbeta4 gene-silenced cells. PMID: 27521796
- Developed an innovative biotechnological method for thymosin beta4 production that employs the peptide acetylation in vivo. PMID: 27015974
- Serum thymosin beta4 concentrations were correlated with the occurrence and severity of obstructive sleep apnea syndrome. PMID: 27086675
- Overexpression of Tbeta4 enhanced cell proliferation and colony formation in oral squamous cell carcinoma. PMID: 26276576
- Tbeta-4 was validated in clinical samples using a tissue microarray to predict overall survival in colon cancer patients PMID: 26556858
- this study demonstrated, for the first time, that Tbeta4 was down-regulated in ROS-stimulated PDLCs as well as Tbeta4 activation exhibited anti-inflammatory effects and anti-osteoclastogenesis in vitro. PMID: 26789270
- this study demonstrates, for the first time, that Tbeta4 is expressed in developing periodontal tissue and that its expression is associated with osteoblastic/cementoblastic differentiation. PMID: 26361868
- This article reviews the potential role of thymosin beta 4 in liver fibrosis by describing the effects of exogenous and endogenous thymosin beta 4 , and discusses the possible signaling pathway regulated by TB4X. [review] PMID: 26006229
- The results of the present study suggested that Tb4 may promote HB metastasis via the induction of EMT, and that Tb4 may therefore be a target for the development of novel treatments for patients with Hepatoblastoma . PMID: 25695679
- these results suggest that NO could regulate the expression of Tbeta4 by direct or indirect effect of HIF-1alpha on Tbeta4 promoter. PMID: 25271630
- the exchange of bound actin between Tbeta4 and profilin involves both steric and allosteric components. PMID: 25313062
- Thymosin beta4 induces invasion and migration of human colorectal cancer cells through the ILK/AKT/beta-catenin signaling pathway. PMID: 25218472
- Regarding HCC, Tbeta4 reactivity was detected in 7/23 cases (30%) and Tbeta10 reactivity in 22/23 (97%) cases analyzed, adding HCC to human cancers that express these beta-thymosins. PMID: 24704991
- Thymosin beta-4 levels in the serum and synovial fluid of knee osteoarthritis patients are significantly correlated with disease severity. PMID: 23816466
- Thymosin beta 4 silencing in glioblastoma cells inhibits cell migration and invasion. PMID: 24355709
- cell trafficking of thymosin beta-4 PMID: 23967050
- Tbeta4 expression was upregulated significantly in primary and recurrent colorectal cancers PMID: 24098025
- Tbeta4 expression was also co-localized with CD133 expression in primary ovarian carcinomas. PMID: 23055022
- Detection its amino acid conservation suggest an important role of Tb4 in the homeostasis of the mammalian oral cavity. PMID: 23262355
- Thymosin beta4 could be associated with morphogenesis and tumor invasion in ameloblastoma and may play a role in the behavior of ameloblastoma. PMID: 23235961
- Tbeta4 plays a key role in odontoblastic differentiation of human dental pulp cells. PMID: 23613983
- Tbeta4 is an important myocardin-related transcription factor (MRTF) regulator that controls the G-actin-MRTF-A interaction.Tbeta4 competed with MRTF-A for G-actin binding, thus interfering with G-actin-MRTF-A complex formation. PMID: 23811404
- REVIEW: role of Tbeta4 in thrombosis and platelet aggregation PMID: 22944663
- Thymosin beta4 expression reveals intriguing similarities between fetal and cancer cells. PMID: 23045970
- investigated whether GSK-3 activity is regulated by thymosin beta-4 (Tbeta4) and associated with Tbeta4-mediated migration in gastric cancer cells; expression of GSK-3alpha, beta-catenin and E-cadherin could be negatively regulated by Tbeta4 induced ERK phosphorylation; suggests that Tbeta4 could be a novel regulator to control Wnt signal pathway PMID: 22328534
- The Our data confirm the concept that externally added Tbeta4 must be internalized to induce intracellular mechanisms supporting endothelial cell migration. PMID: 22652458
- Thymosin beta4 Tbeta4 may play an important role in bone degradation and inflammation in RA but not OA. PMID: 22004227
- kininogen-1 and thymosin-beta(4) are potential new biomarkers for human chronic hepatitis C. PMID: 21496200
- Tbeta4 is regulated by IL-18 and is involved in IL-18-enhanced IFN-gamma secretion in NK cells. PMID: 21742406
- Elevated expression of thymosin beta4 is associated with early-stage cervical cancers. PMID: 21213129
- Thymosin beta4 may play a role in diabetic retinal neovascularization. PMID: 21332672
- findings suggest that Tbeta4 by sequestering actin prevents binding of AKT, thus inhibiting its phosphorylation PMID: 21514425
- The expression of thymosin beta4 is highly related with tumorigenesis of certain tumors including the osteosarcoma and colorectal cancers. PMID: 20975530
- Describe beta-thymosins in bronchoalveolar lavage fluid and their possible involvement in the pathogenesis of scleroderma lung disease. PMID: 21314931
- we have identified an extracellular signaling pathway where Tbeta4 increases cell surface ATP levels via ATP synthase and have shown further that ATP-responsive P2X4 receptor is required for Tbeta4-induced cell migration PMID: 21106936
- overexpression of Tbeta4 is strongly associated with HIF-1alpha and HIF-2alpha expression and is also clinicopathologically involved with lymph node metastatic potential of breast cancer PMID: 21109953
- The TB4 could be a hypoxia responsive regulator to control tumor cell migration in angiogenesis and tumor metastasis. PMID: 20821256
- colorectal cancer stem cells from different patients have higher Tbeta4 levels than normal epithelial cells PMID: 20566622
- Data in colon cancer tissue microarray showed that thymosin beta4 and HIF-1alpha co-localized in these biopsies. PMID: 20691219
- Data show a strong expression of Tbeta(4) in gut and endocrine pancreas during development. PMID: 20161756
- study demonstrated a clear relationship between reductions in serum thymosin beta4 level and severity of hepatitis B virus-related liver failure PMID: 20128033
- Data show that thymosin beta4 was differentially expressed in HGF-treated HUVECs compared with control. PMID: 12163032
- araC regulates the transcriptional level of thymosin beta4 and actin PMID: 12962156
- in response to T beta 4 stimulation, AP-1 activity increases to enhance PAI-1 transcription through its unique AP-1-like element at -59 to -52 in the PAI-1 promoter. PMID: 14592829
- upregulation of Tbeta-4, by promoting the disruption of cell-cell adhesion and consequential activation of the beta-catenin signaling, could be event in the acquisition of growth advantages as well as invasive phenotypes in human colorectal carcinomas PMID: 15235586
- activated factor XIII incorporates thymosin beta(4) into the isolated gamma-module and alphaC-domain (fibrinogen A alpha); in fibrin the latter serves as the major incorporation site PMID: 15311936
顯示更多
收起更多
-
亞細胞定位:Cytoplasm, cytoskeleton.
-
蛋白家族:Thymosin beta family
-
組織特異性:Expressed in several hemopoietic cell lines and lymphoid malignant cells. Decreased levels in myeloma cells.
-
數(shù)據(jù)庫鏈接:
Most popular with customers
-
-
YWHAB Recombinant Monoclonal Antibody
Applications: ELISA, WB, IHC, IF, FC
Species Reactivity: Human, Mouse, Rat
-
Phospho-YAP1 (S127) Recombinant Monoclonal Antibody
Applications: ELISA, WB, IHC
Species Reactivity: Human
-
-
-
-
-